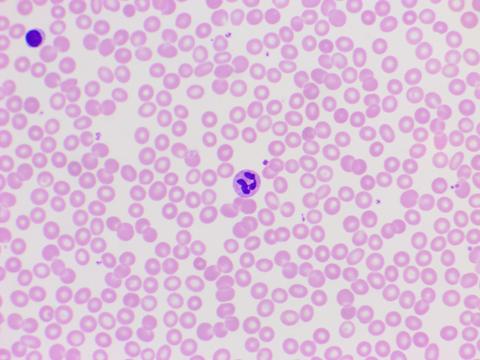
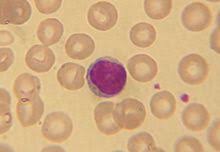

As a student of character, I have neither given or received unauthorized aid on this assessment.
What blood cells are shown here? Choose all correct answers.

What blood cell is shown here? Choose all correct answers.

What percentage of blood is composed of plasma?
What is the name of the stem cell that creates the erythrocytes, leukocytes, and thrombocytes?
What two organs filter out dead erthrocytes?
What is the name of the waste molecule created from the breakdown of erythrocytes?
What organ secretes erythropoietin (EPO)?
Which hematocrit value is in the middle of the range for males?
What three cells are shown here? Choose all correct responses.
Which leukocyte's function is to phagocytize bacteria?
Which leukocyte's function is to attack viruses?
Which leukocyte's function is to destroy parasitic worms?
Which leukocyte's function is to release histamine and heparin?
Which leukocyte targets all types of pathogens?
Which blood type(s) will contain plasma with Anti-B antibodies?
Which blood type(s) can donate to all other blood types/universal donor?
Which blood type has only B antigens and the Rh factor?
Which blood type(s) can recieve O+ blood in a transfusion?
Which blood type(s) can receive A- blood in a transfusion?
What blood type is shown below?
What blood type is shown below?




What blood cells are shown here? Choose all correct answers.
What blood cell is shown here indicated with a black arrow? Choose all correct terms for the cell indicated with the black arrow.

What blood cells are shown here? Choose all correct answers.

What blood cells are shown here? Choose all correct answers.

What blood cells are shown here? Choose all correct answers.
